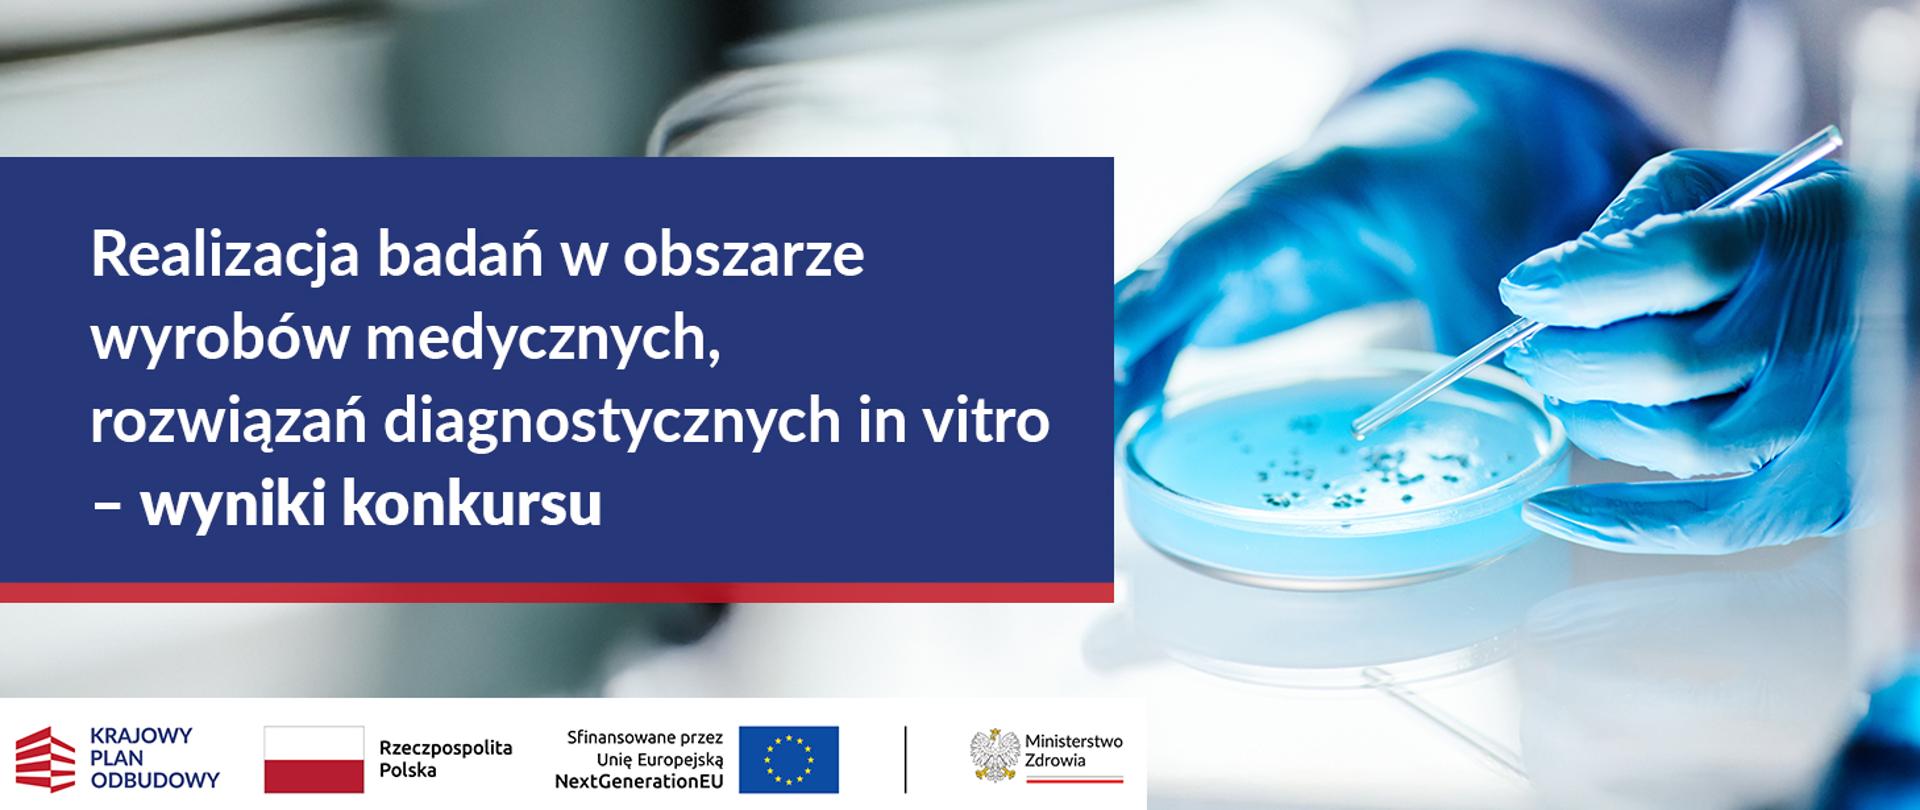
invitro wyniki konkursu

Wyniki konkursu dla przedsiębiorców na realizację badań w obszarze wyrobów medycznych, rozwiązań diagnostycznych in vitro
12.02.2025
Ministerstwo Zdrowia powierzyło Agencji Badań Medycznych realizację konkursu dla przedsiębiorców na realizację badań w obszarze wyrobów medycznych, rozwiązań diagnostycznych in vitro (2024/ABM/06/KPO).
Prezes Agencji Badań Medycznych, prof. dr hab. n. med. Wojciech Fendler, zatwierdził listę rankingową konkursu. Spośród 23 złożonych wniosków, po ocenie formalnej, merytorycznej i finansowej, dofinansowanie na łączną kwotę 26 176 682,92 zł otrzymało 7 przedsięwzięć.
Konkurs realizowany jest w ramach Krajowego Planu Odbudowy i Zwiększania Odporności, Komponentu D: Efektywność, dostępność i jakość systemu ochrony zdrowia, Inwestycji D3.1.1: Kompleksowy rozwój badań w zakresie nauk medycznych i nauk o zdrowiu.
Jego głównym celem jest podniesienie efektywności systemu ochrony zdrowia poprzez rozwój krajowego potencjału badawczo-rozwojowego. W wyniku konkursu wsparcie finansowe otrzymają przedsiębiorcy działający w sektorze biomedycznym, realizujący projekty związane z rozwojem wyrobów medycznych oraz rozwiązań diagnostycznych. Wybrane inicjatywy przyczynią się do wzmocnienia prewencji, usprawnienia diagnostyki, poprawy skuteczności leczenia oraz rehabilitacji pacjentów. Realizacja projektów stanowi istotny krok w kierunku wzmacniania innowacyjności sektora ochrony zdrowia oraz poprawy dostępności nowoczesnych technologii medycznych na rynku krajowym i europejskim, zgodnie z założeniami Rządowego Planu Rozwoju Sektora Biomedycznego na lata 2022–2031.
Decyzje wraz z recenzjami zostaną przekazane wnioskodawcom niezwłocznie.
Materiały
Lista_rankingowa__2024_ABM_06_KPO_12_02_2025_Lista_rankingowa__2024_ABM_06_KPO_12_02_2025_.pdf 0.19MB
